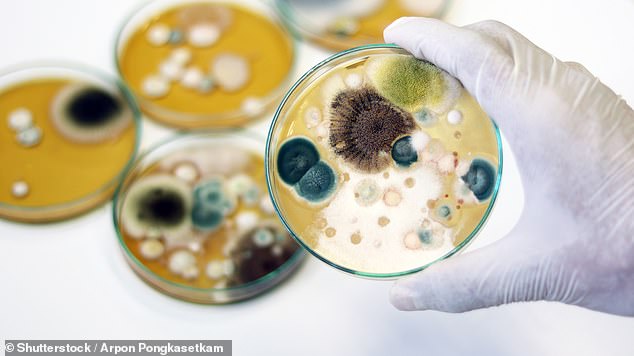
Scientists farted onto a Petri dish to find out if farts contaminate the air with bacteria. The dishes were left overnight and one dish sprouted visible lumps of two types of bacteria that are usually found only in the gut and on the skin

Do Not Fart next to food when you are Naked......

Scientists have farted directly into a Petri dish to find out if faeces floats around afterwards.
This unsophisticated experiment was attempted after an Australian doctor was asked by a nurse whether quietly farting during surgery would contaminate the operating theatre.
Dr Karl Kruszelnicki told listeners to his science phone-in radio show in Brisbane: 'I realised that I didn't know.
'But I was determined to find out.'
Dr Kruszelnicki contacted his friend Luke Tennent, a microbiologist in Canberra, who then got a colleague to fart two inches away from a Petri dish.
The experiment was carried out once while wearing clothes and another with no pants on.
+5
View gallery
Scientists farted onto a Petri dish to find out if farts contaminate the air with bacteria. The dishes were left overnight and one dish sprouted visible lumps of two types of bacteria that are usually found only in the gut and on the skin
Dishes were left overnight.
One dish sprouted visible growths of two types of bacteria that are usually found only in the gut and on the skin, which were splattered onto the dish by the force of the fart.
But the fart that had passed through clothing had no effect, suggesting the trousers acted as a filter, reported the
journal BMJ.
Dr Kruszelnicki told the Canberra Times in 2001: 'The enteric zone in the second Petri dish was caused by the flatus itself, and the splatter ring around that was caused by the sheer velocity of the fart, which blew skin bacteria from the cheeks and blasted it onto the dish.
'It seems, therefore, that flatus can cause infection if the emitter is naked, but not if he or she is clothed.'
But the scientists stressed the results should not be considered alarming because the bacteria found was not harmful.
In fact, it was similar to the 'friendly' bacteria found in yoghurt, but they did suggest it was probably best if you didn't 'fart naked near food'.
 Do Not Fart next to food when you are Naked......
Do Not Fart next to food when you are Naked......
....
.... forgot to post this last night
forgot to post this last night 





